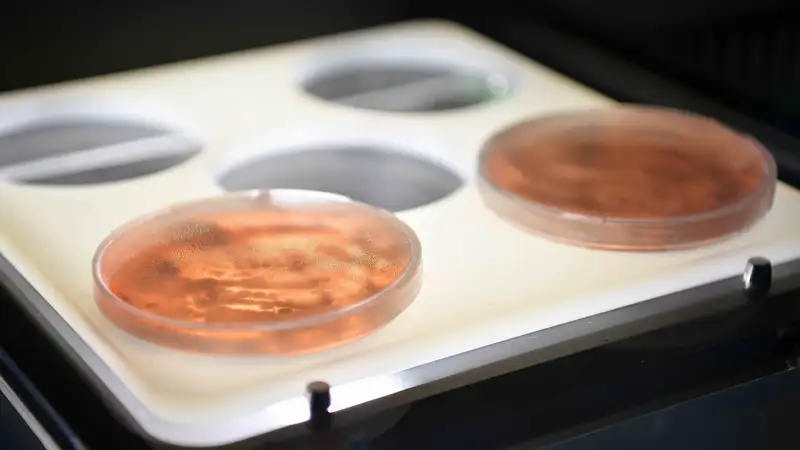
Су тасқыны салдарынан жұқпалы аурулардың пайда болу қаупі бар ма: ДСМ мәлімдеме жасады

"Көптеген өңірлерде жағдай көңіл көншітпейді": қазақстандықтарға ауыз су сапасына қатысты үндеу жасалды
 Фото: freepik
Фото: freepik
Ведомствоның дерегінше, лас су – тек жағымсыз дәм мен иіс қана емес, ол инфекциялық ауруларға, созылмалы дерттерге, тіпті өлім жағдайларына алып келетін елеулі қауіп.
Суымыздың құрамында не жасырынуы мүмкін? Таза ауыз су мөлдір, иіссіз, дәмсіз болып, қатаң санитариялық талаптарға сай келуі тиіс. Алайда іс жүзінде су құрамында қауіпті қоспалар кездеседі: микробтар, химиялық заттар, радиоактивті заттар.
Орталықтандырылған су жүйелерінде жыл сайын жүргізілетін тексерулер нәтижесінде судың басым бөлігі санитариялық талаптарға сәйкес келетіні анықталады. Дегенмен, орта есеппен алғанда сынамалардың 1–3%-ы микробиологиялық көрсеткіштер бойынша, ал 3–8%-ы химиялық құрам бойынша талапқа сай болмай шығады. Бұл тіпті орталықтандырылған су жүйесі бар қала мен ауылдарда да ластанған суды пайдалану қаупі бар екенін көрсетеді.
Ал ауылдық жерлерде тұрғындар көбіне құдық пен бұлақ суын пайдаланады. Мұндай сулар табиғи құрамында темір, магний сияқты заттарды қамтиды. Ұзақ уақыт бойы осындай суды тұтыну денсаулыққа кері әсерін тигізеді.
Өзіңізді және жақындарыңызды қорғау үшін не істеу керек?
- су сүзгілерін пайдаланыңыз: суды зиянды қоспалардан тазарту үшін пәтеріңізге немесе үйіңізге су сүзгісін орнатыңыз.
- суды қайнатыңыз: егер сіз судың сапасына сенімді болмасаңыз, оны 10-15 минут қайнатыңыз.
– бөтелкедегі суды пайдаланыңыз:таза суға қол жеткізе алмасаңыз, бөтелкедегі суды пайдаланыңыз.
- судың сапасын үнемі тексеріп отырыңыз:егер сіз ұңғымадан немесе бұлақтан суды қолдансаңыз, оның сапасын зертханада үнемі тексеріп отырыңыз.
- су ресурстарын қорғау бастамаларын қолдаңыз: өзендер мен көлдерді тазарту акцияларына қатысыңыз, су ресурстарын қорғау ұйымдарына қолдау көрсетіңіз.
2025 жылғы 8 қыркүйекте халыққа Жолдауында Президент Қасым-Жомарт Тоқаев қазіргі кезде біз табиғи су тапшылығына тап болып отырғанымызды, сондай-ақ оны тұтыну мәдениетінің деңгейі көңіл көншітпейтінін атап өтті.